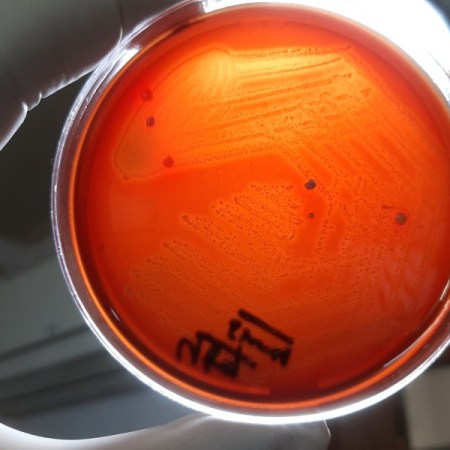

Categoría: Informes


Enfermedad Inflamatoria Intestinal: 70 mil argentinos la padecen

Hipertensión: prevenir, controlar y educar

Estudian el rol de ciertas levaduras en la prevención de infección por Salmonella

Alquileres: El índice de actualización de contratos de locación iniciados en junio será del 80,36%
Microbiología clínica: La vigilancia genómica del ANLIS reconocida internacionalmente

El CATSPBA socializó una nueva contribución en «Intersecciones»: relación entre la problemática socioambiental y el trabajo social

ASMA: Una enfermedad prevenible que aún mata

Un análisis de sangre podría orientar decisiones en el tratamiento del cáncer
